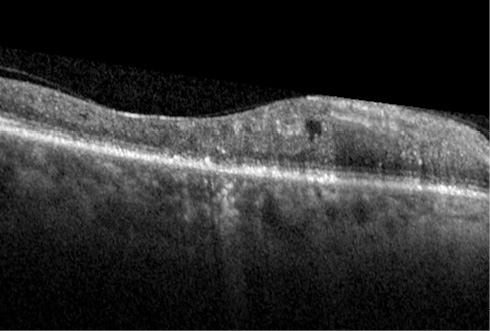

Choroidal melanoma is a malignant tumor of the eye that is typically treated with some form of radiotherapy, such as plaque radiotherapy.1 This treatment can lead to cataract, retinopathy, or maculopathy, all of which may result in reduced visual acuity.2 One of the most common causes of visual acuity loss following radiation therapy is radiation retinopathy or maculopathy, a condition that often develops when radiation exposure continues beyond tissue tolerance,3 which can lead to irreversible blindness.4
AT A GLANCE
• Treatment of choroidal melanoma with radiotherapy can lead to other conditions, such as cataract, radiation maculopathy, or radiation retinopathy.
• Both radiation maculopathy and retinopathy can be treated with anti-VEGF injections and/or focal laser therapy.
• Micropulse laser delivers short bursts of low energy pulses divided by rest periods; the cooling period prevents tissue damage, and the treatment may stimulate a restorative response.
Treatment for radiation maculopathy typically includes scheduled intravitreal anti-VEGF injections, usually either bevacizumab (Avastin, Genentech) or ranibizumab (Lucentis, Genentech).5 Studies have shown intravitreal bevacizumab injections to decrease macular edema and produce moderate increases in visual acuity; however, lasting effects have not been demonstrated.6 Focal laser therapy may also moderately improve visual acuity, but, again, studies have shown benefits to be short term.7
Unlike conventional laser therapy, in micropulse laser technology a continuous-wave laser beam is broken into short bursts of low energy pulses interspersed with brief rest periods. These rest periods allow the tissue to cool between laser bursts, which prevents tissue damage and produces outcomes that are equal or superior to conventional laser treatment.8-11 Because the tissue remains viable, it is possible that the treatment stimulates a restorative response, triggering regeneration in healthy cells and creating longer-lasting positive outcomes. Consider the following patient case.
RADIATION RETINOPATHY WITH MACULAR EDEMA
A 48-year-old woman was diagnosed with severe radiation retinopathy in her right eye after receiving plaque radiotherapy to treat choroidal melanoma. Her visual acuity prior to plaque removal in June 2005 was 20/30. In March 2007, fluorescein angiography showed leakage in the macula indicating the development of macular edema. The patient was treated with an injection of bevacizumab. At the time, her visual acuity was 20/100 and declining.
No macular edema was detected in January 2008, but in September of that year, the patient’s condition had deteriorated to counting fingers. Despite being given another injection of bevacizumab, followed by four more over the next 9 months, her visual acuity never improved beyond 20/400.

Figure 1. After treatment for radiation retinopathy, the CRT of this patient’s eye remained at 510 μm.
Figure 2. After multiple anti-VEGF injections, CRT decreased to 386 μm, at which point micropulse laser was performed, lowering CRT to 316 μm.
In November 2009, the patient underwent focal laser treatment in her right eye. Fluorescein angiography at this time showed florid macular edema. She subsequently received two additional bevacizumab injections over the next 2 months, but her vision never demonstrated improvement. By August 2010, her central retinal thickness (CRT) was 510 μm (Figure 1). She was again treated with focal laser and bevacizumab. Her CRT showed minimal improvement, remaining in the mid to high 400-μm range.
In September 2014, the patient’s CRT measured 386 μm. She was treated with the IQ 577 laser (Iridex) with a standard slit-lamp adaptor using the parameters 400 mW power, 200 μm spot size, 200 ms exposure duration with 100 ms intervals, and 5% duty cycle. A Goldmann 901 macular lens (Haag-Streit) was used for visualization.
At 1 month after the procedure, her CRT had decreased to 316 μm (Figure 2). Since this last treatment, the patient has shown a significant improvement in vision, and the edema is no longer present.
During her most recent visit in June 2015, her CRT was 307 μm. Fluorescein angiography showed no leakage, although her visual acuity was still 20/400, most likely due to the degeneration of photoreceptors prior to treatment. However, for the first time, the patient perceived improved vision. She has received no further treatment.
CONCLUSION
The success of the treatment in this case could be due to the fact that the patient’s edema was subfoveal and had been difficult to reach with conventional laser. With micropulse laser, we were able to maneuver much closer to the fovea. The significant improvement in anatomy and in her perception of vision was dramatic. Despite years of treatment with traditional laser and anti-VEGF agents, this patient’s condition had continued to deteriorate. One micropulse laser treatment has left her retina in an anatomically near-perfect state. n
1. Shields JA, Shields CL. Posterior uveal melanoma: management. In: Intraocular Tumors: An Atlas and Textbook. 2nd ed. Philadelphia, PA: Lippincott Williams and Wilkins; 2008;140-141.
2. Gündüz K, Shields CL, Shields JA, et al. Radiation complications and tumor control after plaque radiotherapy of choroidal melanoma with macular involvement. Am J Ophthalmol. 1999;127(5):579-589.
3. Horgan N, Shields CL, Mashayekhi A, Shields JA. Classification and treatment of radiation maculopathy. Curr Opin Ophthalmol. 2010;21(3):233-238.
4. Finger PT, Kurli M. Laser photocoagulation for radiation retinopathy after ophthalmic plaque radiation therapy. Br J Ophthalmol. 2005;89(6):730-738.
5. Finger PT. Radiation retinopathy is treatable with anti-vascular endothelial growth factor bevacizumab (Avastin). Int J Radiat Oncol Biol Phys. 2008;70(4):974-977.
6. Mason JO 3rd, Albert MA Jr, Persaud TO, Vail RS. Intravitreal bevacizumab treatment for radiation macular edema after plaque radiotherapy for choroidal melanoma. Retina. 2007;27(7):903-907.
7. Hykin PG, Shields CL, Shields JA, Arevalo JF. The efficacy of focal laser therapy in radiation-induced macular edema. Ophthalmology. 1998;105(8):1425-1429.
8. Vujosevic S, Bottega E, Casciano M, et al. Microperimetry and fundus autofluorescence in diabetic macular edema: subthreshold micropulse diode laser versus modified Early Treatment Diabetic Retinopathy Study laser photocoagulation. Retina. 2010;30(6):908-916.
9. Lavinsky D, Cardillo JA, Melo LA Jr, et al. Randomized clinical trial evaluating mETDRS versus normal or high-density micropulse photocoagulation for diabetic macular edema. Invest Ophthalmol Vis Sci. 2011;52(7):4314-4323.
10. Gupta B, Elagouz M, McHugh D, et al. Micropulse diode laser photocoagulation for central serous chorioretinopathy. Clin Experiment Ophthalmol. 2009;37(8):801-805.
11. Inagaki K, Ohkoshi K, Ohde S, et al. Subthreshold micropulse photocoagulation for persistent macular edema secondary to branch retinal vein occlusion including best-corrected visual acuity greater than 20/40. J Ophthalmol. 2014;2014:251257.
Robert L. Halpern, MD
• retina surgeon at Eye Consultants of Atlanta in Atlanta, Ga., specializing in serious ocular conditions; director of the fellowship program at Eye Consultants of Atlanta; chairman of the section of ophthalmology at Piedmont Hospital in Atlanta, Ga.
• financial interest: none acknowledged
• retinarob@yahoo.com
Margaret Wong, MD
• board certified uveitis and retina surgeon with the Eye Consultants of Atlanta in Atlanta, Ga.
• financial interest: none acknowledged
• margaret.oph@gmail.com









_1773249222.png?auto=compress,format&w=75)










